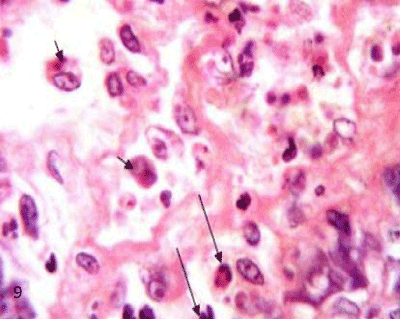

|
| Figure 9: A photomicrograph of rat pancreatic tissue of the diabetic group showing the inflammatory cells infiltration inside the islet (long arrows). Noticed cellular residues within the cytoplasm of phagocytic cells (short arrows). The phagocytic cells are surrounded by empty spaces. (HX&E X1000). |